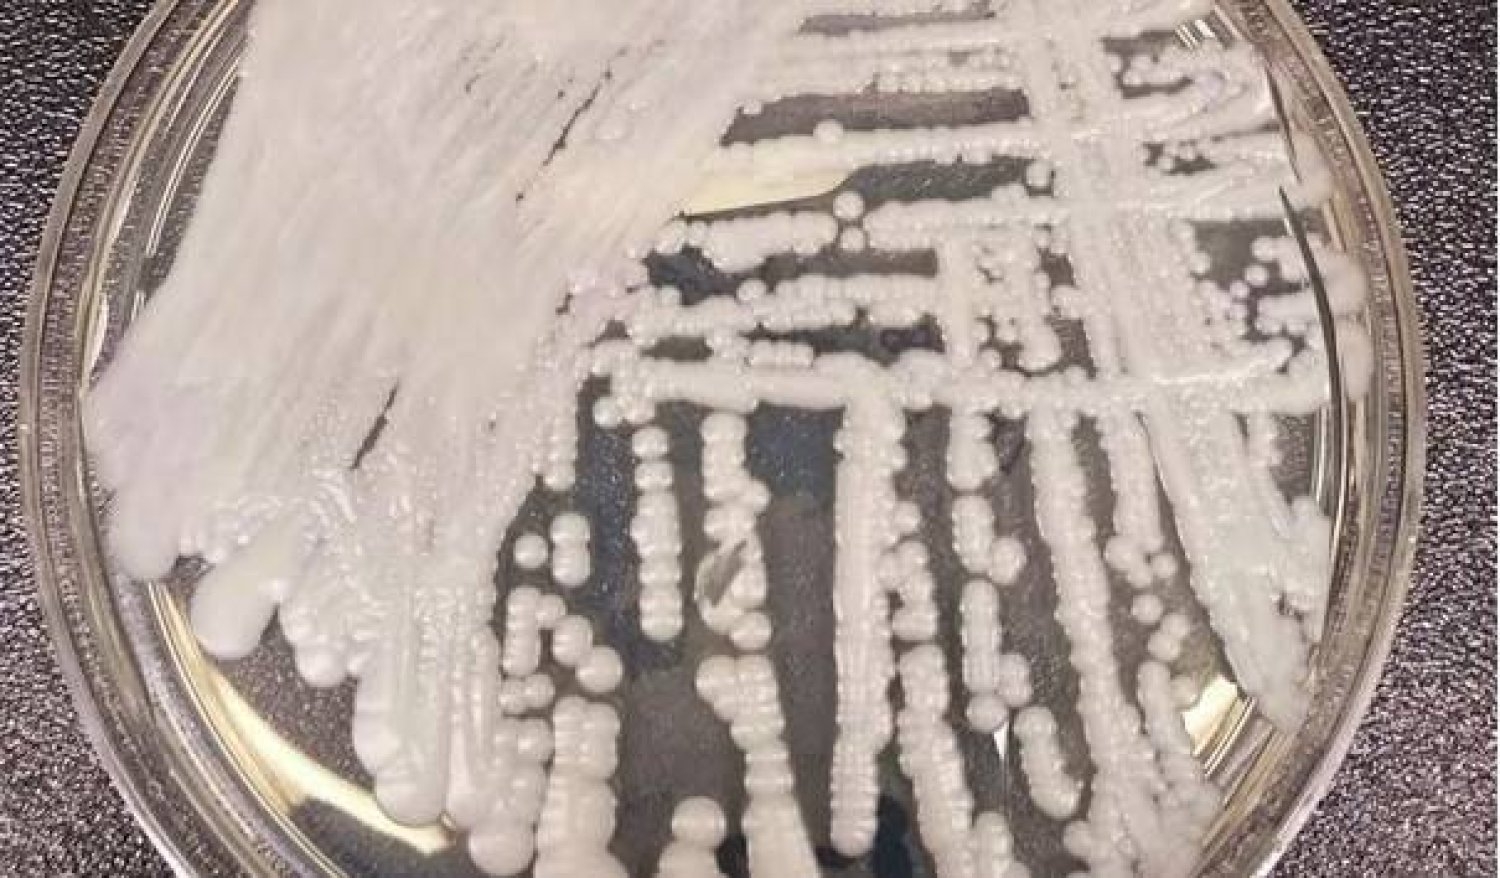
اكتشاف خميرة قد توقف الالتهابات الفطرية

اكتشاف خميرة قد توقف الالتهابات الفطرية
اكتشف علماء نوعًا جديدًا من الخميرة في أمعاء الفئران والبشر يمكن أن تكون لها فوائد صحية ملحوظة.
ويبدو أن النوع الجديد الذي أطلق عليه الباحثون اسم «Kazachstania weizmannii»، يقاوم خميرة أخرى تسمى Candida albicans، والتي لديها القدرة على الانتشار إلى عدوى فطرية خطيرة.
وتعيش (المبيضة البيضاء) على جلد العديد من الأشخاص والأغشية المخاطية دون إزعاج كبير، على الرغم من أن فرط نموها يمكن أن يسبب حالة مزعجة من داء المبيضات (المعروف عادة باسم مرض القلاع).
وفي بعض الظروف، كما هو الحال عند الأشخاص الذين يعانون من نقص المناعة، يمكن أن تسبب المبيضات البيضاء «داء المبيضات الغازي»؛ وهي عدوى حادة ومميتة في كثير من الأحيان للأعضاء الداخلية والتي تنتشر بسهولة في أماكن الرعاية الصحية.
ومن المبشر أن «K. weizmannii» يبدو أنه يساعد في إبقاء C. albicans تحت السيطرة، حتى في الفئران ذات الأجهزة المناعية الضعيفة.
ومن أجل المزيد من التوضيح، قال المؤلف الرئيسي للدراسة الجديدة عالم المناعة ستيفن يونج «قد يكون لهذه المنافسة بين أنواع كازاخستان والمبيضات قيمة علاجية لإدارة الأمراض البشرية التي تسببها المبيضة البيضاء. فالكائنات الحية الدقيقة التي تعيش فينا وعلينا دون التسبب في ضرر هي جزء من الميكروبيوم المتعايش. كما ان المعلومات الجينية، أو الميتاجينوم، التي تجعلنا بشرًا تأتي من الخلايا البشرية والميكروبيوم المتعايش». وذلك وفق ما نقل موقع «ساينس إليرت» عن «Journal of Experimental Medicine».
وفي هذا الاطار، تمت دراسة الميتاجينوم من حيث البكتيريا العديدة التي تعيش على الأسطح المخاطية، لكن الفطريات تعيش هناك أيضًا، ولا يُعرف سوى القليل عن دورها في الصحة.
وتظهر الأدلة المتزايدة أن الفطريات المتعايشة، وخاصة المبيضة البيضاء، يمكن أن تقوي أجهزة المناعة لدى الثدييات. كما أنه قد يتم تطوير علاجات أفضل من خلال فهم أفضل لكيفية تأثير الفطريات المتعايشة على المناعة، وهذا ما بدأ الباحثون بالتحقيق فيه.
جدير بالذكر، تحتوي الفئران البرية على المبيضة البيضاء في المتفطرات الخاصة بها، لكن فئران المختبر التي يتم الاحتفاظ بها في ظروف معقمة نادرًا ما تحتوي عليها، وعادةً لا تسمح للمبيضة البيضاء باستعمارها دون علاج بالمضادات الحيوية لقتل البكتيريا الأخرى التي تمنعها. لكن يونج وزملاءه لاحظوا أن بعض نماذج الفئران التي تعاني من عوز المناعة لا يمكن استعمارها بالمبيضة البيضاء حتى بعد العلاج بالمضادات الحيوية. ثم وجدوا أن الكائنات الحية الدقيقة في أمعاء هذه الفئران تحمل أنواعًا غير محددة من الخميرة.
ويبين يونج «مع العلم أن المبيضة البيضاء يمكن أن تسبب مرضًا يهدد الحياة، قررنا إجراء مزيد من التحقيق في هذا الأمر. وبالفعل، فقد أتى هذا الخط من البحث بثماره، حيث وجدنا أن الخميرة الجديدة يمكن أن تمنع بقوة استعمار المبيضة البيضاء».
ولعل النتيجة الأكثر أهمية هي أن الباحثين اكتشفوا أن K. weizmannii يمكن أن يقلل من عدد بكتيريا C. albicans في أمعاء الفئران عن طريق التنافس معها على شغل الأمعاء؛ ففي الفئران التي تعاني من عوز المناعة، يمكن أن تتسلل المبيضة البيضاء عبر الحاجز المعوي. وأيضا يمكن أن يحدث داء المبيضات الغازي عندما تدخل الخميرة إلى مجرى الدم وتنتشر، ما يؤثر على العديد من أعضاء الجسم بما في ذلك العينان والعظام والقلب والدماغ. لكن إدخال K. weizmannii أدى إلى تأجيل انتشار داء المبيضات الغازي في هذه الفئران إلى حد كبير.
ويشرح يونج قائلا «بفضل قدرته على التنافس بنجاح مع المبيضة البيضاء في أمعاء الفأر، قلل K. weizmannii من وجود المبيضة البيضاء وخفف من تطور داء المبيضات في الحيوانات المثبطة للمناعة».
وقد حدد الفريق أيضًا K. weizmannii وأنواعًا مماثلة في عينات ميتاجينوم الأمعاء البشرية، حيث لم يتم العثور على نوعي Kazachstania وCandida معًا في كثير من الأحيان. وهذا يعني أن النوعين قد يتنافسان أيضًا في الأمعاء البشرية، على الرغم من أن هناك حاجة إلى مزيد من الأبحاث للتأكد.
الشرق الاوسط















